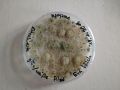
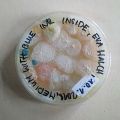
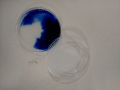

BACTERIA INTERACTION WITH PAINTING
In this class I was researching, how bacteria grow. How they differ, depending on the media. I also tried to combine drawings with bacteria
Painting with bacteria on paper
In this first try I started with cooking the standart medium out of Miga`s protocol. I also started with figuring out how the medium and bacteria are behaving on paper. Therefor I was cluing the some drawings on some stable underground, to prevent them from rolling, when they are getting wet
Medium recipe (source: Miga’s protocol)
- Glucose – 10 g
- Peptone – 2.5 g
- Yeast extract – 2.5 g
- Na2HPO4 – 1.35 g
- Citric acid – 0.75 g
- Distilled water – 500 ml
- Agar – 7.5 g
After three day you can see, that the bacteria are growing more on the paper than on the medium, there is maybe no need for the agar in the medium because maybe the nutrients were soaked into the paper. (--> see second try without agar)
After 2,5 weeks it changed and the bacteria were growing strong on the medium
But still I tried to une the same medium but without agar
It looks like there is probably not enough liquid, so it did not really work without agar and I went on with the standard medium and started to figure out how I can control the bacteria (see experiment further below)
When I had a little more knowledge I also tried to let grow two extracted bacteria on two different parts on the drawing. I used some darker, blue bacteria for the mushroom (1) and some green/white looking ones for the surrounding (2).
But sadly it did not really work. Maybe it would be more successful if I do not only use two different kind of bacteria, because they somehow also could move to and other parts of the picture just through the air, but also use two different kind of media.
Media experiments:
In these tries, I was starting to figure out how I can let grow diffenent kind of bacteria. One way is to change the ph-level of the medium (source: Wikipedia [1]):
"Unter Selektivnährboden versteht man einen Nährboden, der das Wachstum einer bestimmten Gruppe von Mikroorganismen, beispielsweise bestimmter Bakterien, begünstigt während er die Entwicklung anderer Mikroorganismen unterdrückt. Dies geschieht aufgrund der Zusammensetzung des Nährbodens, da Mikroorganismen unterschiedliche Bedürfnisse hinsichtlich des Kulturmediums in puncto Nährstoffzusammensetzung, pH-Wert etc. besitzen und da einige Stoffe andere Mikroorganismen in ihrem Wachstum hemmen."
Here I tried to cook media with different kind of acidity
- in the first petri dish there is the medium for the Growth of Gluconacetobacter but without citric acid
- in the second petri dish there is the standart medium for the growth of Gluconacetobacter, which includes some citric acid
- the third petri dish contains the medium for the growth of Gluconacetobacter, but with the double the amound of citric acid
So I found out, that with to less acidity there is nothing really happening and with more acidity than usual there are no more bacteria growing, but fungi.
What I also realized, is that you can play with the different kind of sugar you are using to cook the medium.
It makes a big different, if you use glucose or fructose, but also you can use for example potato starch.
Furthermore I was trying to extract two different bacteria into two different petri dishes to have to clean bacteria to be able to paint with them
Coloring bacteria and media:
In this experiment I try to color bacteria after they grown, by putting red pigment to the bacteria
After one week:
So how you can see, the bacteria does not absorb the color. That's probably because there are two different kind of bacteria, one whose cell wall allows it to absorb color, and the other one doesn`t.
I also tried to put ink into the medium, so that it became blue. But after heating it up in the microwave the blue color disappeared.
But still the bacteria were growing different than on the normal medium, somehow more intense, maybe because there is more bakteria inside with the added ink
In the second try, I put ink into the medium, but after the heating in the microwave
It looks like that the bacteria is growing much faster on the part of the medium, where there is no ink. But also where the ink is there are growing bacteria.
It also seems like they are soaking in the color.
Further steps:
Now it would be interesting to let grow different bacteria in the same petri dish. Therefore I would use different kind of media, that means using different kind of sugar, and also playing with the acidity. Furthermore I could choose between the extracted bacteria, depending on what kind of bacteria I want to have on which part of the petri dish.